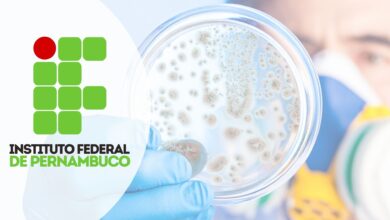
Curso agente comunitário de Saúde

15 de dezembro de 2025
IFG Lança Edital Com Centenas de Vagas Para Especialização Gratuita e EAD em Sustentabilidade e Educação!
IFG Abre Seleção para Pós-Graduação EAD em Educação, Meio Ambiente e Sustentabilidade O Instituto Federal de Educação, Ciência e Tecnologia…
15 de dezembro de 2025
MBA ou Especialização? IFRS Lança 2 Editais para Cursos 100% Gratuitos de Pós-Graduação
Oportunidades no Campus Feliz são para as áreas de Gestão Empresarial e Gestão Escolar; saiba como se inscrever online e…
15 de dezembro de 2025
SENAI e Petrobras abrem inscrições para cursos que pagam bolsa para você estudar!
O Programa Autonomia e Renda Petrobras, em parceria com o Firjan SESI e executado pelo SENAI SP, publicou o edital…
15 de dezembro de 2025
Curso Técnico em Tradução e Intepretação de LIBRAS é aposta do IFNMG; Inscrições abertas!
O Instituto Federal do Norte de Minas Gerais (IFNMG), através do Campus Teófilo Otoni, acaba de lançar uma excelente oportunidade…